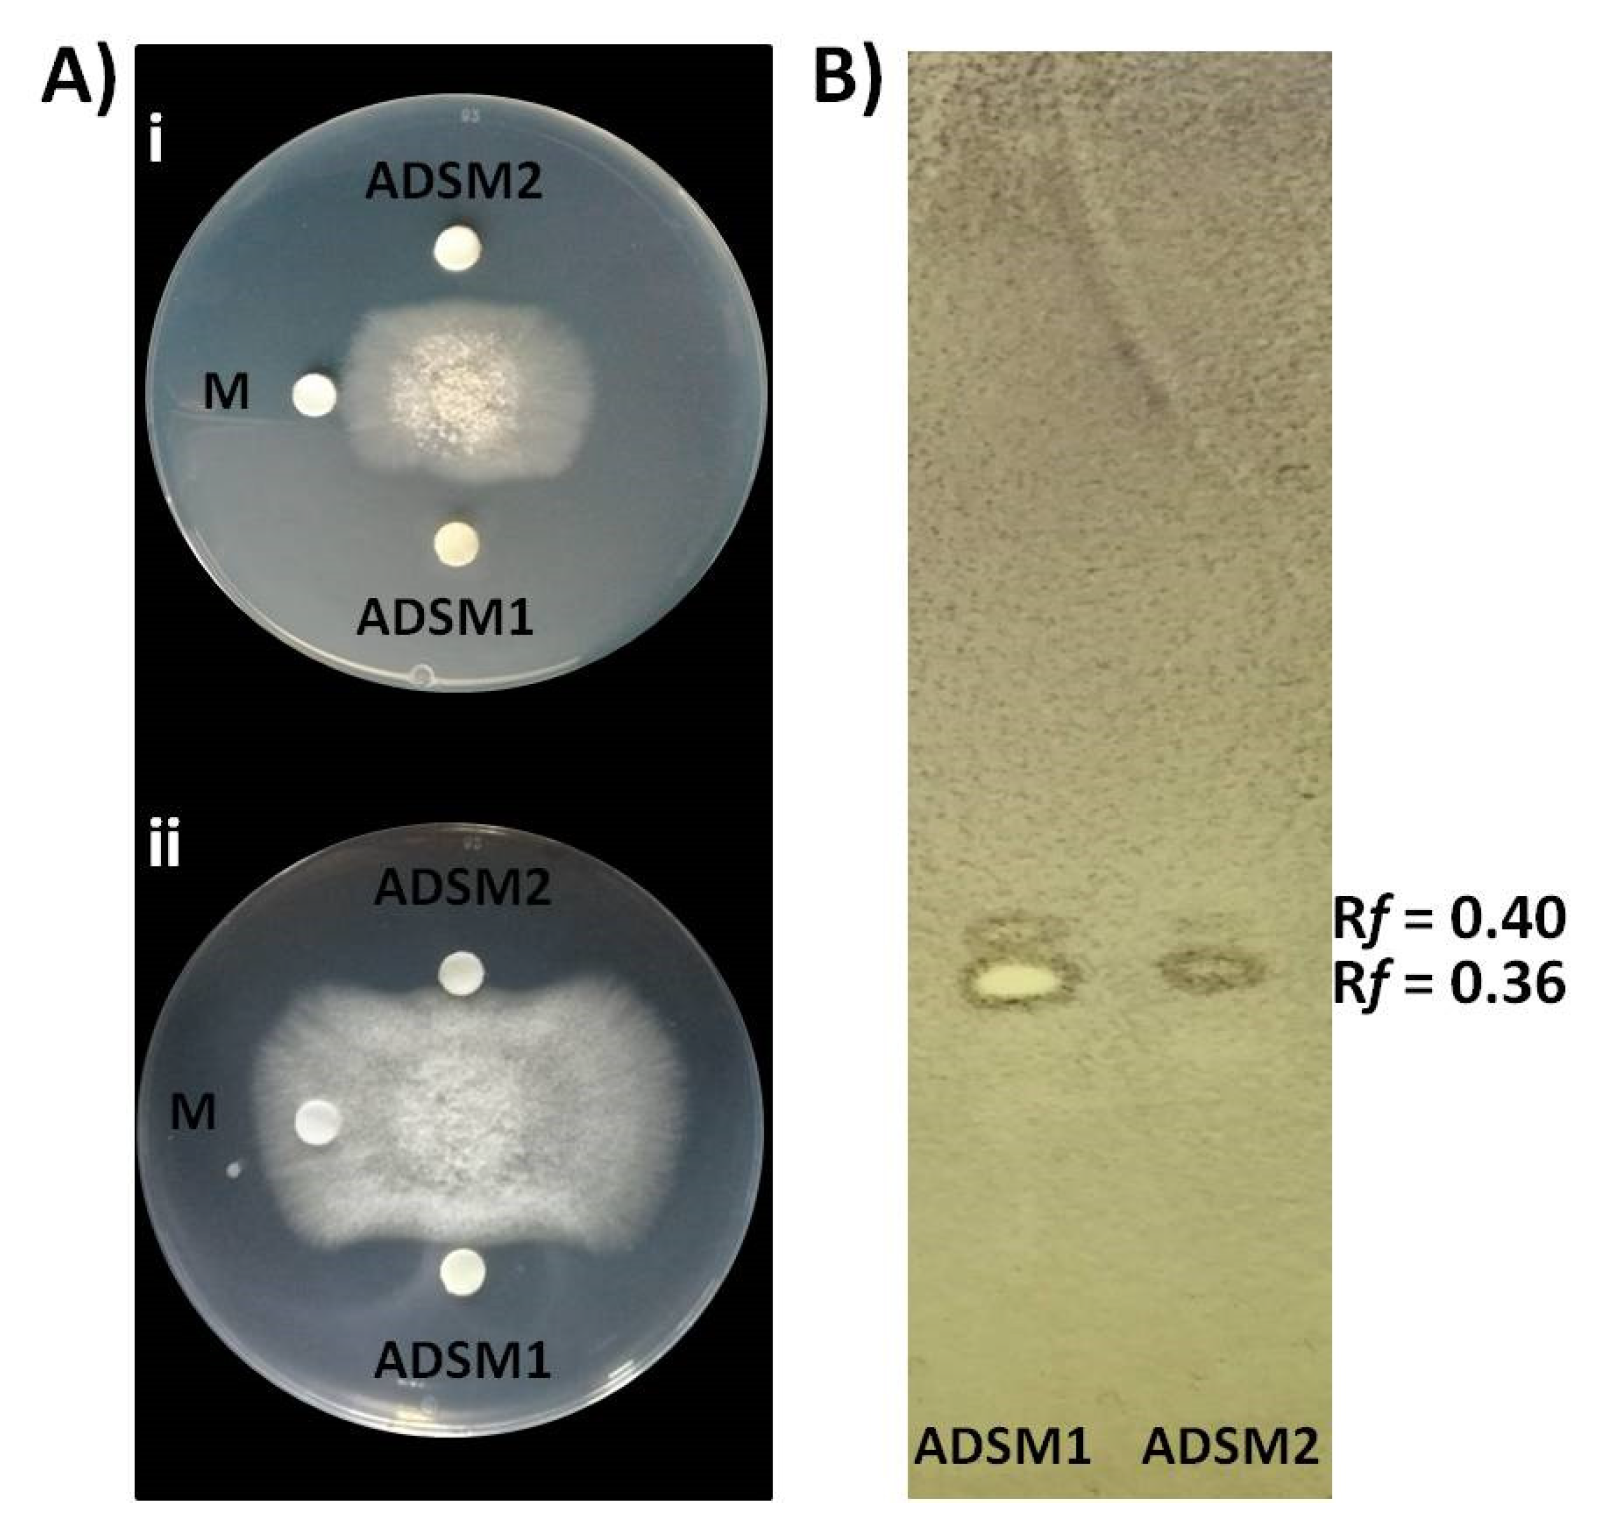
Microorganisms 10 00399 g007 550

Integrated Genomic and Metabolomic Analysis Illuminates Key Secreted Metabolites Produced by the Novel Endophyte Bacillus halotolerans Cal.l.30 Involved in Diverse Biological Control Activities
Abstract
:1. Introduction
2. Materials and Methods
2.1. Dual Culture Assay
2.2. Drop Collapse Assay
2.3. Detached Fruit Assay
2.4. Colonization on Wounded Grape Berries and Tomato Fruits
2.5. Extraction of Agar-Diffusible Secondary Metabolites of Cal.l.30
2.6. Antagonistic Activity of Agar-Diffusible Secondary Metabolites of Cal.l.30 against B. cinerea In Vitro
2.7. TLC-bioautography Assay of Cal.l.30 Secreted Compounds
2.8. Ultra-High Performance Liquid Chromatography Orbitrap High-Resolution Mass Spectrometry Analysis
2.9. Genome Sequencing
2.10. Functional Genome Analysis
2.11. Statistical Analysis
3. Results
3.1. Biological Control Activity of Bacillus Strains from Calendula officinalis
3.2. Biological Control Potential of Endophytic Bacillus Strain Cal.l.30 against Botrytis cinerea
3.3. Genomic Features and Taxonomic Classification of Cal.l.30, Cal.f.4 and Cal.l.11
3.4. Genomic Insights into the Antifungal Activity and Biocontrol Potential of Cal.l.30
3.5. Predicted Secondary Metabolite BGC Richness in B. halotolerans Genomes
3.6. Analysis of CAZyme Genes in B. halotolerans Stain Cal.l.30 Genome
3.7. Constitutive Production and Secretion of Agar-Diffusible Antifungal Metabolites of Cal.l.30 When Grown on a Solid Surface
4. Discussion
5. Conclusions
Author Contributions
Funding
Institutional Review Board Statement
Informed Consent Statement
Data Availability Statement
Conflicts of Interest
References
- Lugtenberg, B.; Kamilova, F. Plant-growth-promoting rhizobacteria. Annu. Rev. Microbiol. 2009, 63, 541–556. [Google Scholar] [CrossRef] [PubMed] [Green Version]
- Raymaekers, K.; Ponet, L.; Holtappels, D.; Berckmans, B.; Cammue, B.P.A. Screening for novel biocontrol agents applicable in plant disease management–A review. Biol. Control 2020, 144, 104240. [Google Scholar] [CrossRef]
- Santoyo, G.; Moreno-Hagelsieb, G.; del Carmen Orozco-Mosqueda, M.; Glick, B.R. Plant growth-promoting bacterial endophytes. Microbiol. Res. 2016, 183, 92–99. [Google Scholar] [CrossRef] [PubMed]
- Ongena, M.; Jacques, P. Bacillus lipopeptides: Versatile weapons for plant disease biocontrol. Trends Microbiol. 2008, 16, 115–125. [Google Scholar] [CrossRef] [PubMed]
- Shafi, J.; Tian, H.; Ji, M. Bacillus species as versatile weapons for plant pathogens: A review. Biotechnol. Biotechnol. Equip. 2017, 31, 446–459. [Google Scholar] [CrossRef] [Green Version]
- Caulier, S.; Gillis, A.; Colau, G.; Licciardi, F.; Liépin, M.; Desoignies, N.; Modrie, P.; Legrève, A.; Mahillon, J.; Bragard, C. Versatile antagonistic activities of soil-borne Bacillus spp. and Pseudomonas spp. against Phytophthora infestans and other potato pathogens. Front. Microbiol. 2018, 9, 143. [Google Scholar] [CrossRef]
- Fira, D.; Dimkić, I.; Berić, T.; Lozo, J.; Stanković, S. Biological control of plant pathogens by Bacillus species. J. Biotechnol. 2018, 285, 44–55. [Google Scholar] [CrossRef]
- Caulier, S.; Nannan, C.; Gillis, A.; Licciardi, F.; Bragard, C.; Mahillon, J. Overview of the antimicrobial compounds produced by members of the Bacillus subtilis group. Front. Microbiol. 2019, 10, 302. [Google Scholar] [CrossRef] [Green Version]
- Ichikawa, N.; Sasagawa, M.; Yamamoto, M.; Komaki, H.; Yoshida, Y.; Yamazaki, S.; Fujita, N. DoBISCUIT: A database of secondary metabolite biosynthetic gene clusters. Nucleic Acids Res. 2012, 41, D408–D414. [Google Scholar] [CrossRef] [Green Version]
- Lastochkina, O.; Seifikalhor, M.; Aliniaeifard, S.; Baymiev, A.; Pusenkova, L.; Garipova, S.; Kulabuhova, D.; Maksimov, I. Bacillus spp.: Efficient biotic strategy to control postharvest diseases of fruits and vegetables. Plants 2019, 8, 97. [Google Scholar] [CrossRef] [Green Version]
- Slama, H.B.; Cherif-Silini, H.; Chenari Bouket, A.; Qader, M.; Silini, A.; Yahiaoui, B.; Alenezi, F.N.; Luptakova, L.; Triki, M.A.; Vallat, A. Screening for Fusarium antagonistic bacteria from contrasting niches designated the endophyte Bacillus halotolerans as plant warden against Fusarium. Front. Microbiol. 2019, 9, 3236. [Google Scholar] [CrossRef] [PubMed] [Green Version]
- Wang, F.; Xiao, J.; Zhang, Y.; Li, R.; Liu, L.; Deng, J. Biocontrol ability and action mechanism of Bacillus halotolerans against Botrytis cinerea causing grey mould in postharvest strawberry fruit. Postharvest Biol. Technol. 2021, 174, 111456. [Google Scholar] [CrossRef]
- Wu, X.; Wu, H.; Wang, R.; Zhengqi, Z.; Zhang, Y.; Gu, Q.; Farzand, A.; Yang, X.; Semenov, M.; Borriss, R.; et al. Genomic Features and Molecular Function of a Novel Stress-Tolerant Bacillus halotolerans Strain Isolated from an Extreme Environment. Biology 2021, 10, 1030. [Google Scholar] [CrossRef]
- Kefi, A.; Slimene, I.B.; Karkouch, I.; Rihouey, C.; Azaeiz, S.; Bejaoui, M.; Belaid, R.; Cosette, P.; Jouenne, T.; Limam, F. Characterization of endophytic Bacillus strains from tomato plants (Lycopersicon esculentum) displaying antifungal activity against Botrytis cinerea Pers. World J Microbiol Biotechnol. 2015, 31, 1967–1976. [Google Scholar] [CrossRef] [PubMed]
- Farzand, A.; Moosa, A.; Zubair, M.; Khan, A.R.; Hanif, A.; Tahir, H.A.S.; Gao, X. Marker assisted detection and LC-MS analysis of antimicrobial compounds in different Bacillus strains and their antifungal effect on Sclerotinia sclerotiorum. Biol. Control. 2019, 133, 91–102. [Google Scholar] [CrossRef]
- Sagredo-Beltrán, J.; De La Cruz-Rodríguez, Y.; Alvarado-Rodríguez, M.; Vega-Arreguín, J.; Rodríguez-Guerra, R.; Alvarado-Gutiérrez, A.; Fraire-Velázquez, S. Genome sequence of Bacillus halotolerans strain MS50- 18A with antifungal activity against phytopathogens, isolated from saline soil in San Luís Potosí, Mexico. Genome Announc. 2018, 6, e00135-e18. [Google Scholar] [CrossRef] [PubMed] [Green Version]
- Wu, H.; Gu, Q.; Xie, Y.; Lou, Z.; Xue, P.; Fang, L.; Yu, C.; Jia, D.; Huang, G.; Zhu, B.; et al. Cold-adapted Bacilli isolated from the Qinghai-Tibetan Plateau are able to promote plant growth in extreme environments. Environ. Microbiol. 2019, 21, 3505–3526. [Google Scholar] [CrossRef]
- Thomloudi, E.-E.; Tsalgatidou, P.C.; Baira, E.; Papadimitriou, K.; Venieraki, A.; Katinakis, P. Genomic and Metabolomic Insights into Secondary Metabolites of the Novel Bacillus halotolerans Hil4, an Endophyte with Promising Antagonistic Activity against Gray Mold and Plant Growth Promoting Potential. Microorganisms 2021, 9, 2508. [Google Scholar] [CrossRef]
- Droby, S.; Lichter, A. Post-harvest Botrytis infection: Etiology, development and management. In Botrytis: Biology, Pathology and Control; Elad, Y., Williamson, B., Tudzynski, P., Delen, N., Eds.; Springer: Dordrecht, The Netherlands, 2007; pp. 349–367. [Google Scholar]
- Köhl, J.; Postma, J.; Nicot, P.; Ruocco, M.; Blum, B. Stepwise screening of microorganisms for commercial use in biological control of plant-pathogenic fungi and bacteria. Biol. Control. 2011, 57, 1–12. [Google Scholar] [CrossRef]
- Comby, M.; Gacoin, M.; Robineau, M.; Rabenoelina, F.; Ptas, S.; Dupont, J.; Profizi, C.; Baillieul, F. Screening of wheat endophytes as biological control agents against Fusarium head blight using two different in vitro tests. Microbiol. Res. 2017, 202, 11–20. [Google Scholar] [CrossRef]
- Köhl, J.; Medeiros, F.H.; Lombaers-van der Plas, C.; Groenenboom-de Haas, L.; van den Bosch, T. Efficacies of bacterial and fungal isolates in biocontrol of Botrytis cinerea and Pseudomonas syringae pv. tomato and growth promotion in tomato do not correlate. Biol. Control. 2020, 150, 104375. [Google Scholar] [CrossRef]
- Perez, M.F.; Ibarreche, J.P.; Isas, A.S.; Sepulveda, M.; Ramallo, J.; Dib, J.R. Antagonistic yeasts for the biological control of Penicillium digitatum on lemons stored under export conditions. Biol. Control. 2017, 115, 135–140. [Google Scholar] [CrossRef]
- Zhang, X.; Zhou, Y.; Li, Y.; Fu, X.; Wang, Q. Screening and characterization of endophytic Bacillus for biocontrol of grapevine downy mildew. Crop. Prot. 2017, 96, 173–179. [Google Scholar] [CrossRef]
- Tsalgatidou, P.; Thomloudi, E.E.; Venieraki, A.; Katinakis, P. Plant growth promoting endophytic bacteria (PGPEB) from Calendula officinalis-Effect on plant growth and root architecture of Arabidopsis thaliana Col-0. In Proceedings of the 28th International Symposium of CIEC, International Scientific Centre for Fertilizers Fertilization and Nutrient Use Efficiency in Mediterranean Environments, Athens, Greece, 3–4 November 2020; pp. 181–185. [Google Scholar]
- Nifakos, K.; Tsalgatidou, P.C.; Thomloudi, E.-E.; Skagia, A.; Kotopoulis, D.; Baira, E.; Delis, C.; Papadimitriou, K.; Markellou, E.; Venieraki, A.; et al. Genomic Analysis and Secondary Metabolites Production of the Endophytic Bacillus velezensis Bvel1: A Biocontrol Agent against Botrytis cinerea Causing Bunch Rot in Post-Harvest Table Grapes. Plants 2021, 10, 1716. [Google Scholar] [CrossRef]
- Etebarian, H.R.; Sholberg, P.L.; Eastwell, K.C.; Sayler, R.J. Biological control of apple blue mold with Pseudomonas fluorescens. Can. J. Microbiol. 2005, 51, 591–598. [Google Scholar] [CrossRef]
- Liu, Y.; Teng, K.; Wang, T.; Dong, E.; Zhang, M.; Tao, Y.; Zhong, J. Antimicrobial Bacillus velezensis HC6: Production of three kinds of lipopeptides and biocontrol potential in maize. J. Appl. Microbiol. 2020, 128, 242–254. [Google Scholar] [CrossRef] [Green Version]
- Townsley, L.; Yannarell, S.M.; Huynh, T.N.; Woodward, J.J.; Shank, E.A. Cyclic di-AMP acts as an extracellular signal that impacts Bacillus subtilis biofilm formation and plant attachment. MBio 2018, 9, e00341-e18. [Google Scholar] [CrossRef] [Green Version]
- Shi, J.F.; Sun, C.Q. Isolation, identification, and biocontrol of antagonistic bacterium against Botrytis cinerea after tomato harvest. Braz. J. Microbiol. 2017, 48, 706–714. [Google Scholar] [PubMed]
- Barratt, R.; Horsfall, J. An improved grading system for measuring plant disease. Phytopathology 1945, 35, 655. [Google Scholar]
- Bock, C.H.; Gottwald, T.R.; Parker, P.E.; Cook, A.Z.; Ferrandino, F.; Parnell, S.; Van den Bosch, F. The Horsfall-Barratt scale and severity estimates of citrus canker. Eur. J. Plant Pathol. 2009, 125, 23–38. [Google Scholar] [CrossRef]
- Nutter, F.W.; Esker, P.D. The role of psychophysics in phytopathology: The Weber–Fechner law revisited. Eur. J. Plant Pathol. 2006, 114, 199–213. [Google Scholar] [CrossRef]
- Calvo, H.; Mendiara, I.; Arias, E.; Blanco, D.; Venturini, M.E. The role of iturin A from B. amyloliquefaciens BUZ-14 in the inhibition of the most common postharvest fruit rots. Food Microbial. 2019, 82, 62–69. [Google Scholar] [CrossRef] [PubMed] [Green Version]
- Bankevich, A.; Nurk, S.; Antipov, D.; Gurevich, A.A.; Dvorkin, M.; Kulikov, A.S.; Lesin, V.M.; Nikolenko, S.I.; Pham, S.; Prjibelski, A.D. SPAdes: A new genome assembly algorithm and its applications to single-cell sequencing. J. Comput. Biol. 2012, 19, 455–477. [Google Scholar] [CrossRef] [Green Version]
- Meier-Kolthoff, J.P.; Göker, M. TYGS is an automated high-throughput platform for state-of-the-art genome-based taxonomy. Nat. Commun. 2019, 10, 2182. [Google Scholar] [CrossRef]
- Meier-Kolthoff, J.P.; Auch, A.F.; Klenk, H.-P.; Göker, M. Genome sequence-based species delimitation with confidence intervals and improved distance functions. BMC Bioinform. 2013, 14, 60. [Google Scholar] [CrossRef] [Green Version]
- Yoon, S.-H.; Ha, S.-M.; Kwon, S.; Lim, J.; Kim, Y.; Seo, H.; Chun, J. Introducing EzBioCloud: A taxonomically united database of 16S rRNA gene sequences and whole-genome assemblies. Int. J. Syst. Evol. Microbiol. 2017, 67, 1613. [Google Scholar] [CrossRef]
- Blin, K.; Shaw, S.; Steinke, K.; Villebro, R.; Ziemert, N.; Lee, S.Y.; Medema, M.H.; Weber, T. antiSMASH 5.0: Updates to the secondary metabolite genome mining pipeline. Nucleic Acids Res. 2019, 47, W81–W87. [Google Scholar] [CrossRef] [Green Version]
- Benson, D.A.; Cavanaugh, M.; Clark, K.; Karsch-Mizrachi, I.; Lipman, D.J.; Ostell, J.; Sayers, E.W. GenBank. Nucleic Acids Res. 2013, 41, D36–D42. [Google Scholar] [CrossRef] [Green Version]
- Medema, M.H.; Kottmann, R.; Yilmaz, P.; Cummings, M.; Biggins, J.B.; Blin, K.; De Bruijn, I.; Chooi, Y.H.; Claesen, J.; Coates, R.C. Minimum information about a biosynthetic gene cluster. Nat. Chem. Biol. 2015, 11, 625–631. [Google Scholar]
- Zhang, Z.; Yin, L.; Li, X.; Zhang, C.; Liu, C.; Wu, Z. The complete genome sequence of Bacillus halotolerans ZB201702 isolated from a drought-and salt-stressed rhizosphere soil. Microb. Pathog. 2018, 123, 246–249. [Google Scholar] [CrossRef]
- Heo, J.; Kim, S.-J.; Kim, J.-S.; Hong, S.-B.; Kwon, S.-W. Complete genome sequence of Bacillus halotolerans F41-3 isolated from wild flower in Korea. Microbiol. Soc. Korea 2019, 55, 306–308. [Google Scholar]
- Wu, W.; Chen, W.; Liu, S.; Wu, J.; Zhu, Y.; Qin, L.; Zhu, B. Beneficial Relationships Between Endophytic Bacteria and Medicinal Plants. Front. Plant Sci. 2021, 12, 758. [Google Scholar] [CrossRef] [PubMed]
- Fincheira, P.; Quiroz, A. Microbial volatiles as plant growth inducers. Microbiol. Res. 2018, 208, 63–75. [Google Scholar] [CrossRef] [PubMed]
- Adamek, M.; Spohn, M.; Stegmann, E.; Ziemert, N. Mining bacterial genomes for secondary metabolite gene clusters. In Antibiotics; Humana Press: New York, NY, USA, 2017; pp. 23–47. [Google Scholar]
- Adamek, M.; Alanjary, M.; Sales-Ortells, H.; Goodfellow, M.; Bull, A.T.; Winkler, A.; Wibberg, D.; Kalinowski, J.; Ziemert, N. Comparative genomics reveals phylogenetic distribution patterns of secondary metabolites in Amycolatopsis species. BMC Genom. 2018, 19, 426. [Google Scholar] [CrossRef] [PubMed] [Green Version]
- Dunlap, C.A.; Bowman, M.J.; Rooney, A.P. Iturinic lipopeptide diversity in the Bacillus subtilis species group–important antifungals for plant disease biocontrol applications. Front Microbiol. 2019, 10, 1794. [Google Scholar] [CrossRef] [PubMed] [Green Version]
- Ma, Z.; Wang, N.; Hu, J.; Wang, S. Isolation and characterization of a new iturinic lipopeptide, mojavensin A produced by a marine-derived bacterium Bacillus mojavensis B0621A. J. Antibiot. 2012, 65, 317–322. [Google Scholar] [CrossRef] [PubMed] [Green Version]
- Luo, C.; Zhou, H.; Zou, J.; Wang, X.; Zhang, R.; Xiang, Y.; Chen, Z. Bacillomycin L and surfactin contribute synergistically to the phenotypic features of Bacillus subtilis 916 and the biocontrol of rice sheath blight induced by Rhizoctonia solani. Appl. Microbiol. Biotechnol. 2015, 99, 1897–1910. [Google Scholar] [CrossRef] [PubMed]
- Wang, D.; Xu, Z.; Zhang, G.; Xia, L.; Dong, X.; Li, Q.; Liles, M.R.; Shao, J.; Shen, Q.; Zhang, R. A genomic island in a plant beneficial rhizobacterium encodes novel antimicrobial fatty acids and a self-protection shield to enhance its competition. Environ. Microbiol. 2019, 21, 3455–3471. [Google Scholar] [CrossRef]
- Torres, M.J.; Brandan, C.P.; Petroselli, G.; Erra-Balsells, R.; Audisio, M.C. Antagonistic effects of Bacillus subtilis subsp. subtilis and B. amyloliquefaciens against Macrophomina phaseolina: SEM study of fungal changes and UV-MALDI-TOF MS analysis of their bioactive compounds. Microbiol. Res. 2016, 182, 31–39. [Google Scholar] [CrossRef]
- Moldenhauer, J.; Götz, D.C.; Albert, C.R.; Bischof, S.K.; Schneider, K.; Süssmuth, R.D.; Engeser, M.; Gross, H.; Bringmann, G.; Piel, J. The final steps of bacillaene biosynthesis in Bacillus amyloliquefaciens FZB42: Direct evidence for beta, gamma dehydration by a trans-acyltransferase polyketide synthase. Angew. Chem. Int. Ed. Engl. 2010, 49, 1465–1467. [Google Scholar] [CrossRef]
- Schneider, K. Strukturaufklärung der Proximicine, Furan-Analoga des Netropsins aus dem marinen Actinomyceten Verrucosispora und Untersuchungen zur Sekundärmetabolitproduktion des pflanzenwachstumsfördernden Bacillus amyloliquefaciens FZB42. Ph.D. Thesis, Technische Universität Berlin, Fakultät II–Mathematik und Naturwissenschaften, Berlin, Gemany, 2007. [Google Scholar]
- Parker, J.B.; Walsh, C.T. Action and timing of BacC and BacD in the late stages of biosynthesis of the dipeptide antibiotic bacilysin. Biochemistry 2013, 52, 889–901. [Google Scholar] [CrossRef] [PubMed] [Green Version]
- Javvadi, S.G.; Cescutti, P.; Rizzo, R.; Lonzarich, V.; Navarini, L.; Licastro, D.; Guarnaccia, C.; Venturi, V. The spent culture supernatant of Pseudomonas syringae contains azelaic acid. BMC Microbiol. 2018, 18, 199. [Google Scholar] [CrossRef] [PubMed] [Green Version]
- Cheon, H.I.; Yeo, M.S.; Kim, K.M.; Kang, J.S.; Pyo, J. Determination of siderophore from Bacillus mojavensis using liquid chromatography quadrupole time-of-flight tandem mass spectrometry. J. Life Sci. 2019, 29, 19. [Google Scholar]
- Daniels, A.O.; Temikotan, T.; Ibiyemi, D.A. Identification and Charaterization of Fatty Acids, Phytohemical Properties and Antibacterial Effect of the Ethyl Acetate Extract of Piliostigma Reticulatum. J. Biotechnol. Bioeng. 2021, 5, 30–40. [Google Scholar]
- Wanga, L.A. Determination of antibacterial activity of extracts from markhamia lutea, zanthoxylum gilletii and their endophytes against common bean bacterial pathogens. Ph.D. Thesis, Egerton University, Njoro, Kenya, 2018. [Google Scholar]
- Ab Rahman, S.F.S.; Singh, E.; Pieterse, C.M.; Schenk, P.M. Emerging microbial biocontrol strategies for plant pathogens. Plant Sci. 2018, 267, 102–111. [Google Scholar] [CrossRef] [Green Version]
- Abdelshafy Mohamad, O.A.; Ma, J.B.; Liu, Y.H.; Zhang, D.; Hua, S.; Bhute, S.; Hedlund, B.P.; Li, W.; Li, L. Beneficial endophytic bacterial populations associated with medicinal plant Thymus vulgaris alleviate salt stress and confer resistance to Fusarium oxysporum. Front. Plant Sci. 2020, 11, 47. [Google Scholar] [CrossRef]
- Khalid, K.A.; Da Silva, J.T. Biology of Calendula officinalis Linn.: Focus on pharmacology, biological activities and agronomic practices. Med. Aromat. Plant Sci. Biotechnol. 2012, 6, 12–27. [Google Scholar]
- Mohammadi Malek, A.; Ebrahimi, A.; Mahzonieh, M.R.; Lotfalian, S. Antibacterial Activities of Bacterial Endophytes Isolated from Zataria multiflora, Achillea willhelmsii and Calendula officinalis L. against Some Human Nosocomial Pathogens. Zahedan J. Res. Med. Sci. 2016, 18, e2482. [Google Scholar] [CrossRef] [Green Version]
- Dunlap, C.A.; Bowman, M.J.; Schisler, D.A.; Rooney, A.P. Genome analysis shows Bacillus axarquiensis is not a later heterotypic synonym of Bacillus mojavensis; reclassification of Bacillus malacitensis and Brevibacterium halotolerans as heterotypic synonyms of Bacillus axarquiensis. Int. J. Syst. Evol. Microbiol. 2016, 66, 2438–2443. [Google Scholar] [CrossRef] [Green Version]
- Meier-Kolthoff, J.P.; Hahnke, R.L.; Petersen, J.; Scheuner, C.; Michael, V.; Fiebig, A.; Rohde, C.; Rohde, M.; Fartmann, B.; Goodwin, L.A.; et al. Complete genome sequence of DSM 30083(T), the type strain (U5/41(T)) of Escherichia coli, and a proposal for delineating subspecies in microbial taxonomy. Stand Genomic. Sci. 2014, 9, 2. [Google Scholar] [CrossRef] [PubMed] [Green Version]
- Martinez, K.B.; Leone, V.; Chang, E.B. Microbial metabolites in health and disease: Navigating the unknown in search of function. J. Biol. Chem. 2017, 292, 8553–8559. [Google Scholar] [CrossRef] [PubMed] [Green Version]
- Dunlap, C.A.; Bowman, M.J.; Zeigler, D.R. Promotion of Bacillus subtilis subsp. inaquosorum, Bacillus subtilis subsp. spizizenii and Bacillus subtilis subsp. stercoris to species status. Antonie Leeuwenhoek 2020, 113, 1–12. [Google Scholar] [CrossRef] [PubMed]
- Tiwari, P.; Bae, H. Horizontal gene transfer and endophytes: An implication for the acquisition of novel traits. Plants 2020, 9, 305. [Google Scholar] [CrossRef] [PubMed] [Green Version]
- Letzel, A.C.; Li, J.; Amos, G.C.; Millán-Aguiñaga, N.; Ginigini, J.; Abdelmohsen, U.R.; Gaudêncio, S.P.; Ziemert, N.; Moore, B.S.; Jensen, P.R. Genomic insights into specialized metabolism in the marine actinomycete Salinispora. Environ. Microbiol. 2017, 19, 3660–3673. [Google Scholar] [CrossRef]
- Baunach, M.; Chowdhury, S.; Stallforth, P.; Dittmann, E. The landscape of recombination events that create nonribosomal peptide diversity. Mol. Biol. Evol. 2021, 38, 2116–2130. [Google Scholar] [CrossRef]
- Ely, B. Recombination and Gene Loss Occur Simultaneously during Bacterial Horizontal Gene Transfer. PLoS ONE 2020, 15, e0227987. [Google Scholar] [CrossRef]
- Oliveira, P.H.; Touchon, M.; Cury, J.; Rocha, E.P. The chromosomal organization of horizontal gene transfer in bacteria. Nat. Commun. 2017, 8, 841. [Google Scholar] [CrossRef]
- Zukancic, A.; Khan, M.A.; Gurmen, S.J.; Gliniecki, Q.M.; Moritz-Kinkade, D.L.; Maddox, C.W.; Alam, M.T. Staphylococcal Protein A (spa) locus is a hot spot for recombination and horizontal gene transfer in Staphylococcus pseudintermedius. mSphere 2020, 5, e00666-e20. [Google Scholar] [CrossRef]
- Rokas, A.; Mead, M.E.; Steenwyk, J.L.; Raja, H.A.; Oberlies, N.H. Biosynthetic gene clusters and the evolution of fungal chemodiversity. Nat. Prod. Rep. 2020, 37, 868–878. [Google Scholar] [CrossRef]
- Jensen, P.R. Natural products and the gene cluster revolution. Trends Microbial. 2016, 24, 968–977. [Google Scholar] [CrossRef] [Green Version]
- Ma, Z.; Hu, J. Production and characterization of iturinic lipopeptides as antifungal agents and biosurfactants produced by a marine Pinctada martensii-derived Bacillus mojavensis B0621A. Appl. Biochem. Biotechnol. 2014, 173, 705–715. [Google Scholar] [CrossRef] [PubMed]
- Ma, Y.; Xu, M.; Liu, H.; Yu, T.; Guo, P.; Liu, W.; Jin, X. Antimicrobial compounds were isolated from the secondary metabolites of endophytic Gordonia in the intestinal tract of Periplaneta Americana. AMB Express 2021, 11, 111. [Google Scholar] [CrossRef] [PubMed]
- Chen, X.-H.; Scholz, R.; Borriss, M.; Junge, H.; Mögel, G.; Kunz, S.; Borriss, R. Difficidin and bacilysin produced by plant-associated Bacillus amyloliquefaciens are efficient in controlling fire blight disease. J. Biotechnol. 2009, 140, 38–44. [Google Scholar] [CrossRef] [PubMed] [Green Version]
- Patel, P.S.; Huang, S.; Fisher, S.; Pirnik, D.; Aklonis, C.; Dean, L.; Meyers, E.; Fernandes, P.; Mayerl, F. Bacillaene, a novel inhibitor of procaryotic protein synthesis produced by Bacillus subtilis: Production, taxonomy, isolation, physico-chemical characterization and biological activity. J. Antibiot. 1995, 48, 997–1003. [Google Scholar] [CrossRef] [Green Version]
- Um, S.; Fraimout, A.; Sapountzis, P.; Oh, D.C.; Poulsen, M. The fungus-growing termite Macrotermes natalensis harbors bacillaene-producing Bacillus sp. that inhibit potentially antagonistic fungi. Sci. Rep. 2013, 3, 3250. [Google Scholar] [CrossRef]
- Chen, K.; Tian, Z.; Luo, Y.; Cheng, Y.; Long, C.A. Antagonistic activity and the mechanism of Bacillus amyloliquefaciens DH-4 against citrus green mold. Phytopathology 2018, 108, 1253–1262. [Google Scholar] [CrossRef] [Green Version]
- Erega, A.; Stefanic, P.; Dogsa, I.; Danevčič, T.; Simunovic, K.; Klančnik, A.; Smole Možina, S.; Mandic Mulec, I. Bacillaene mediates the inhibitory effect of Bacillus subtilis on Campylobacter jejuni biofilms. Appl. Environ. Microbiol. 2021, 26, e0295520. [Google Scholar] [CrossRef]
- Müller, S.; Strack, S.N.; Hoefler, B.C.; Straight, P.D.; Kearns, D.B.; Kirby, J.R. Bacillaene and sporulation protect Bacillus subtilis from predation by Myxococcus xanthus. Appl. Environ. Microbiol. 2014, 80, 5603–5610. [Google Scholar] [CrossRef] [Green Version]
- Vargas-Bautista, C.; Rahlwes, K.; Straight, P. Bacterial competition reveals differential regulation of the pks genes by Bacillus subtilis. J. Bacteriol. 2014, 196, 717–728. [Google Scholar] [CrossRef] [Green Version]
- Jung, H.W.; Tschaplinski, T.J.; Wang, L.; Glazebrook, J.; Greenberg, J.T. Priming in systemic plant immunity. Science 2009, 324, 89–91. [Google Scholar] [CrossRef]
- Cecchini, N.M.; Roychoudhry, S.; Speed, D.J.; Steffes, K.; Tambe, A.; Zodrow, K.; Konstantinoff, K.; Jung, H.W.; Engle, N.L.; Tschaplinski, T.J. Underground Azelaic Acid–Conferred Resistance to Pseudomonas syringae in Arabidopsis. Mol. Plant-Microbe Interact. 2019, 32, 86–94. [Google Scholar] [CrossRef] [Green Version]
- Korenblum, E.; Dong, Y.; Szymanski, J.; Panda, S.; Jozwiak, A.; Massalha, H.; Meir, S.; Rogachev, I.; Aharoni, A. Rhizosphere microbiome mediates systemic root metabolite exudation by root-to-root signaling. Proc. Natl. Acad. Sci. USA 2020, 117, 3874–3883. [Google Scholar] [CrossRef] [PubMed]
- Köhl, J.; Kolnaar, R.; Ravensberg, W.J. Mode of action of microbial biological control agents against plant diseases: Relevance beyond efficacy. Front. Plant Sci. 2019, 10, 845. [Google Scholar] [CrossRef] [PubMed] [Green Version]
- Yu, S.M.; Lee, Y.H. Genes involved in nutrient competition by Pseudomonas putida JBC17 to suppress green mold in postharvest satsuma mandarin. J. Basic Microbiol. 2015, 55, 898–906. [Google Scholar] [CrossRef]
- Fan, H.; Zhang, Z.; Li, Y.; Zhang, X.; Duan, Y.; Wang, Q. Biocontrol of bacterial fruit blotch by Bacillus subtilis 9407 via surfactin-mediated antibacterial activity and colonization. Front. Microbiol. 2017, 8, 1973. [Google Scholar] [CrossRef]
- Romero, D.; de Vicente, A.; Rakotoaly, R.H.; Dufour, S.E.; Veening, J.W.; Arrebola, E.; Cazorla, F.M.; Kuipers, O.P.; Paquot, M.; Pérez-García, A. The iturin and fengycin families of lipopeptides are key factors in antagonism of Bacillus subtilis toward Podosphaera fusca. Mol. Plant-Microbe Interact. 2007, 20, 430–440. [Google Scholar] [CrossRef] [Green Version]
- Zeriouh, H.; Romero, D.; García-Gutiérrez, L.; Cazorla, F.M.; de Vicente, A.; Pérez-García, A. The iturin-like lipopeptides are essential components in the biological control arsenal of Bacillus subtilis against bacterial diseases of cucurbits. Mol. Plant-Microbe Interact. 2011, 24, 1540–1552. [Google Scholar] [CrossRef] [Green Version]
- Alvarez, F.; Castro, M.; Principe, A.; Borioli, G.; Fischer, S.; Mori, G.; Jofre, E. The plant-associated Bacillus amyloliquefaciens strains MEP218 and ARP23 capable of producing the cyclic lipopeptides iturin or surfactin and fengycin are effective in biocontrol of sclerotinia stem rot disease. J. Appl. Microbiol. 2012, 112, 159–174. [Google Scholar] [CrossRef]
- Snook, M.E.; Mitchell, T.; Hinton, D.M.; Bacon, C.W. Isolation and characterization of Leu7-surfactin from the endophytic bacterium Bacillus mojavensis RRC 101, a biocontrol agent for Fusarium verticillioides. J. Agric. Food Chem. 2009, 57, 4287–4292. [Google Scholar] [CrossRef]
- Tendulkar, S.R.; Saikumari, Y.K.; Patel, V.; Raghotama, S.; Munshi, T.K.; Balaram, P.; Chattoo, B.B. Isolation, purification and characterization of an antifungal molecule produced by Bacillus licheniformis BC98, and its effect on phytopathogen Magnaporthe grisea. Appl. Microbiol. 2007, 103, 2331–2339. [Google Scholar] [CrossRef]
- Arrebola, E.; Sivakumar, D.; Bacigalupo, R.; Korsten, L. Combined application of antagonist Bacillus amyloliquefaciens and essential oils for the control of peach postharvest diseases. Crop Prot. 2010, 29, 369–377. [Google Scholar] [CrossRef] [Green Version]
- Weinberg, E.D. Suppression of bacterial biofilm formation by iron limitation. Med. Hypotheses 2004, 63, 863–865. [Google Scholar] [CrossRef] [PubMed]
- de los Santos-Villalobos, S.; Barrera-Galicia, G.C.; Miranda-Salcedo, M.A.; Peña-Cabriales, J.J. Burkholderia cepacia XXVI siderophore with biocontrol capacity against Colletotrichum gloeosporioides. World J. Microbiol. Biotechnol. 2012, 28, 2615–2623. [Google Scholar] [CrossRef] [PubMed]
- Kannojia, P.; Choudhary, K.K.; Srivastava, A.K.; Singh, A.K. PGPR Bioelicitors: Induced Systemic Resistance (ISR) and Proteomic Perspective on Biocontrol. In PGPR Amelioration in Sustainable Agriculture; Woodhead Publishing: Sawston, UK, 2019; pp. 67–84. [Google Scholar]
- Yu, X.; Ai, C.; Xin, L.; Zhou, G. The siderophore-producing bacterium, Bacillus subtilis CAS15, has a biocontrol effect on Fusarium wilt and promotes the growth of pepper. Eur. J. Soil Biol. 2011, 47, 138–145. [Google Scholar] [CrossRef]
- Santhanam, R.; Menezes, R.C.; Grabe, V.; Li, D.; Baldwin, I.T.; Groten, K. A suite of complementary biocontrol traits allows a native consortium of root-associated bacteria to protect their host plant from a fungal sudden-wilt disease. Mol. Ecol. 2019, 28, 1154–1169. [Google Scholar] [CrossRef]
- Dimopoulou, A.; Theologidis, I.; Liebmann, B.; Kalantidis, K.; Vassilakos, N.; Skandalis, N. Bacillus amyloliquefaciens MBI600 differentially induces tomato defense signaling pathways depending on plant part and dose of application. Sci. Rep. 2019, 9, 19120. [Google Scholar] [CrossRef] [Green Version]
- Pršić, J.; Ongena, M. Elicitors of plant immunity triggered by beneficial bacteria. Front. Plant Sci. 2020, 11, 594530. [Google Scholar] [CrossRef]
- Wu, G.; Liu, Y.; Xu, Y.; Zhang, G.; Shen, Q.; Zhang, R. Exploring elicitors of the beneficial rhizobacterium Bacillus amyloliquefaciens SQR9 to induce plant systemic resistance and their interactions with plant signaling pathways. Mol. Plant-Microbe Interact. 2018, 31, 560–567. [Google Scholar] [CrossRef] [Green Version]
- Waewthongrak, W.; Pisuchpen, S.; Leelasuphakul, W. Effect of Bacillus subtilis and chitosan applications on green mold (Penicilium digitatum Sacc.) decay in citrus fruit. Postharvest Biol. Technol. 2015, 99, 44–49. [Google Scholar] [CrossRef]
- Hadwiger, L.A. Multiple effects of chitosan on plant systems: Solid science or hype. Plant Sci. 2013, 208, 42–49. [Google Scholar] [CrossRef]
- Ongena, M.; Jourdan, E.; Adam, A.; Paquot, M.; Brans, A.; Joris, B.; Arpigny, J.L.; Thonart, P. Surfactin and fengycin lipopeptides of Bacillus subtilis as elicitors of induced systemic resistance in plants. Environ. Microbiol. 2007, 9, 1084–1090. [Google Scholar] [CrossRef] [PubMed]
- Ma, Z.; Hu, J. Plipastatin A1 produced by a marine sediment-derived Bacillus amyloliquefaciens SH-B74 contributes to the control of gray mold disease in tomato. 3 Biotech. 2018, 8, 125. [Google Scholar] [CrossRef] [PubMed]
- Akram, W.; Anjum, T.; Ali, B. Phenylacetic acid is ISR determinant produced by Bacillus fortis IAGS162, which involves extensive re-modulation in metabolomics of tomato to protect against Fusarium wilt. Front. Plant Sci. 2016, 7, 498. [Google Scholar] [CrossRef] [PubMed] [Green Version]
- Kutschera, A.; Dawid, C.; Gisch, N.; Schmid, C.; Raasch, L.; Gerster, T.; Schäffer, M.; Smakowska-Luzan, E.; Belkhadir, Y.; Vlot, A.C.; et al. Bacterial medium-chain 3-hydroxy fatty acid metabolites trigger immunity in Arabidopsis plants. Science 2019, 12, 178–181. [Google Scholar] [CrossRef] [PubMed]
- Morales-Cedeno, L.R.; del Carmen Orozco-Mosqueda, M.; Loeza-Lara, P.D.; Parra-Cota, F.I.; de Los Santos-Villalobos, S.; Santoyo, G. Plant growth-promoting bacterial endophytes as biocontrol agents of pre-and post-harvest diseases: Fundamentals, methods of application and future perspectives. Microbiol. Res. 2021, 242, 126612. [Google Scholar]

| Cluster | BGC Type | Compound | MIBiG ID (Similarity %) | Predicted Size (bp) |
|---|---|---|---|---|
| 1 | NRPS | Surfactin | BGC0000433_c1 (86%) | 65.394 |
| 2 | T1PKS-NRPS | Kalimantacin A | BGC0001532_c1 (20%) | 117.825 |
| 3 | Terpene | Unknown | - | 20.426 |
| 4 | TransAT-PKS-NRPS | Bacillaene | BGC0001089_c1 (100%) | 114.235 |
| 5 | TransAT-PKS-NRPS | Fengycin/ Mojavensin A | BGC0001095_c1 (100%) | 129.752 |
| 6 | Terpene | Unknown | - | 21.898 |
| 7 | T3PKS | Unknown | - | 41.097 |
| 8 | NRPS | Bacillibactin | BGC0000309_c1 (100%) | 49.738 |
| 9 | Other | Bacilysin | BGC0001184_c1 (100%) | 41.418 |
| 10 | Sactipeptide | Subtilosin A | BGC0001184_c1 (100%) | 21.612 |
| CAZyme Categories | Family | Activity | Gene Copy Numbers |
|---|---|---|---|
| Glycoside Hydrolases (GH) | GH0 | - | 1 |
| GH1 | β-glucosidase | 4 | |
| GH3 | β-glucosidase | 1 | |
| GH4 | maltose-6-phosphate glucosidase | 4 | |
| GH5 | cellulase | 1 | |
| GH11 | endo-β-1,4-xylanase | 1 | |
| GH13 | α-amylase | 9 | |
| GH16 | xyloglucan:xyloglucosyltransferase | 1 | |
| GH18 | chitinase | 4 | |
| GH23 | lysozyme type G | 4 | |
| GH26 | β-mannanase | 1 | |
| GH30 | endo-β-1,4-xylanase | 1 | |
| GH32 | invertase | 3 | |
| GH42 | β-galactosidase | 2 | |
| GH43 | β-xylosidase | 4 | |
| GH51 | endoglucanase | 2 | |
| GH53 | endo-β-1,4-galactanase | 1 | |
| GH46 | chitosanase | 2 | |
| GH65 | α,α-trehalase | 1 | |
| GH68 | levansucrase | 1 | |
| GH73 | lysozyme | 2 | |
| GH105 | unsaturated rhamnogalacturonyl hydrolase | 2 | |
| GH126 | α-amylase | 1 | |
| GH171 | peptidoglycan β-N-acetylmuramidase | 1 | |
| Glycosyl Transferases (GT) | GT0 | - | 4 |
| GT1 | UDP-glucuronosyltransferase | 3 | |
| GT2 | cellulose synthase | 13 | |
| GT4 | sucrose synthase | 7 | |
| GT5 | glycogen glucosyltransferase | 1 | |
| GT8 | α-1,3-galactosyltransferase | 1 | |
| GT26 | β-N-acetyl mannosaminuronyltransferase | 1 | |
| GT28 | 1,2-diacylglycerol 3-β-galactosyltransferase | 3 | |
| GT35 | glycogen | 1 | |
| GT51 | murein polymerase | 4 | |
| Carbohydrate Esterases (CE) | CE4 | acetyl xylan esterase | 7 |
| CE7 | acetyl xylan esterase | 1 | |
| CE9 | N-acetylglucosamine 6-phosphate deacetylase | 2 | |
| CE12 | pectin acetylesterase | 3 | |
| CE14 | N-acetyl-1-D-myo-inosityl-2-amino-2-deoxy-α-D-glucopyranoside deacetylase | 1 | |
| Polysaccharide Lyases (PL) | PL1 | pectate lyase | 2 |
| PL3 | pectate lyase | 1 | |
| PL9 | pectate lyase | 1 | |
| PL11 | rhamnogalacturonan endolyase | 2 | |
| PL26 | rhamnogalacturonan exolyase | 1 | |
| Auxiliary Activities (AA) | AA10 | lytic polysaccharide monooxygenases | 1 |
| Carbohydrate-Binding Modules (CBM) | CBM16 | binding to cellulose and glucomannan | 1 |
| CBM50 | attached to various enzymes from families GH18, GH19, GH23, GH24, GH25 and GH73 | 11 | |
| CBM63 | bind cellulose | 1 |
| Antibiotic Compounds | Molecular Formula | Experimental m/z | RT (min) | Δppm | Adduct | Reference or Source |
|---|---|---|---|---|---|---|
| Mojavensin A | C50H77N13O14 | 1082.5617 | 14.66 | -1.13 | [M–H]- | [49] |
| Surfactin A C13 | C51H89N7O13 | 1006.6447 | 22.699 | 1.23 | [M–H]- | [50] |
| Surfactin A C15 | C53H93N7O13 | 1035.683 | 23.945 | 0.57 | [M–H]- | [51] |
| Fengycin A C16 | C72H110N12O20 | 1461.7893 | 16.51 | 1.19 | [M–H]- | [52] |
| Bacillaene A | C34H48N2O6 | 579.3441 | 16.365 | 2.13 | [M–H]- | [53] |
| dihydrobacillaene A | C34H50N2O6 | 581.3597 | 16.24 | 2.04 | [M–H]- | [53] |
| Bacillaene B | C40H58N2O11 | 741.3978 | 14.357 | 2.85 | [M–H]- | [54] |
| Bacillaene C | C44H64N2O14 | 843.4293 | 14.984 | 2.27 | [M–H]- | [54] |
| L-dihydroanticapsin | C9H15NO4 | 200.0923 | 11.395 | 2.83 | [M–H]- | [55] |
| Azelaic acid | C9H16O4 | 187.0969 | 11.022 | 2.21 | [M–H]- | [56] |
| Bacillibactin | C39H42N6O18 | 881.2497 | 11.88 | 2.85 | [M–H]- | [57] |
| 15-hydroxypentadecanoid acid | C15H30O3 | 257.2124 | 17.953 | 4.97 | [M–H]- | [58] |
| 2-hydroxyphenylacetic acid | C8H8O3 | 151.0391 | 9.381 | 0.86 | [M–H]- | [59] |
Publisher’s Note: MDPI stays neutral with regard to jurisdictional claims in published maps and institutional affiliations. |
© 2022 by the authors. Licensee MDPI, Basel, Switzerland. This article is an open access article distributed under the terms and conditions of the Creative Commons Attribution (CC BY) license (https://creativecommons.org/licenses/by/4.0/).
Share and Cite
Tsalgatidou, P.C.; Thomloudi, E.-E.; Baira, E.; Papadimitriou, K.; Skagia, A.; Venieraki, A.; Katinakis, P. Integrated Genomic and Metabolomic Analysis Illuminates Key Secreted Metabolites Produced by the Novel Endophyte Bacillus halotolerans Cal.l.30 Involved in Diverse Biological Control Activities. Microorganisms 2022, 10, 399. https://doi.org/10.3390/microorganisms10020399
Tsalgatidou PC, Thomloudi E-E, Baira E, Papadimitriou K, Skagia A, Venieraki A, Katinakis P. Integrated Genomic and Metabolomic Analysis Illuminates Key Secreted Metabolites Produced by the Novel Endophyte Bacillus halotolerans Cal.l.30 Involved in Diverse Biological Control Activities. Microorganisms. 2022; 10(2):399. https://doi.org/10.3390/microorganisms10020399
Chicago/Turabian StyleTsalgatidou, Polina C., Eirini-Evangelia Thomloudi, Eirini Baira, Konstantinos Papadimitriou, Aggeliki Skagia, Anastasia Venieraki, and Panagiotis Katinakis. 2022. "Integrated Genomic and Metabolomic Analysis Illuminates Key Secreted Metabolites Produced by the Novel Endophyte Bacillus halotolerans Cal.l.30 Involved in Diverse Biological Control Activities" Microorganisms 10, no. 2: 399. https://doi.org/10.3390/microorganisms10020399
APA StyleTsalgatidou, P. C., Thomloudi, E.-E., Baira, E., Papadimitriou, K., Skagia, A., Venieraki, A., & Katinakis, P. (2022). Integrated Genomic and Metabolomic Analysis Illuminates Key Secreted Metabolites Produced by the Novel Endophyte Bacillus halotolerans Cal.l.30 Involved in Diverse Biological Control Activities. Microorganisms, 10(2), 399. https://doi.org/10.3390/microorganisms10020399







